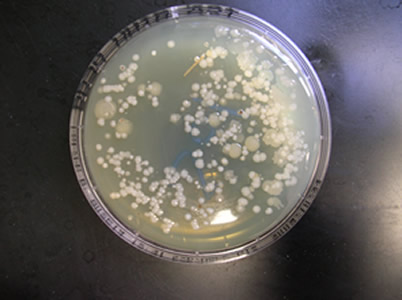
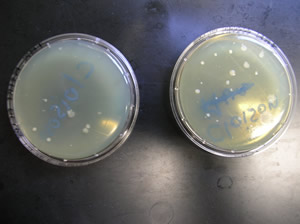
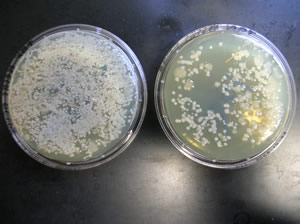

Objectifs de l'étude
Cette étude a pour but de contrôler l'efficacité du nettoyage désinfection des salles de maternité à l'aide de boîtes contact "flore totale" (méthode IFIP).
Elle permettra en outre de refaire le point avec l'éleveur sur sa méthode, la mettre en relation avec les résultats d'analyse (bons ou mauvais) et éventuellement proposer des mesures de correction.
Présentation des élevages
30 élevages bretons (région de Loudéac) ont été sélectionnés.
Un questionnaire sur la pratique du nettoyage désinfection des maternités leur a été remis.
|
||||||||||||||||||||||||
 |
La plupart des éleveurs procèdent à un trempage des salles avant le lavage. Près de la moitié utilisent un détergent.
Les préfosses sont vidées dans 57 % des cas mais en revanche rarement lavées (3 élevages/30).
Presque tous les éleveurs utilisent un désinfectant.
Très peu (2/30) pratiquent une 2ème désinfection.
Enfin, 1/3 utilisent un aérotherme pour sécher les salles avant de rentrer les truies.
La répartition des élevages en fonction du type de sol en maternité est la suivante :
 |
Protocole
La qualité du nettoyage désinfection est évaluée à l'aide de boîtes contact, c'est-à-dire des boîtes de pétri que l'on applique sur une surface (pendant environ 5 secondes en maintenant une légère pression). Après incubation (48 h à 30°C), le nombre de colonies bactériennes est déterminé.
 |
|
Prélèvement
à l'aide de boîtes contact |
Flore
observée après une incubation de 48h à 30°C |
Points de contrôle

Il y a 5 à 7 points de contrôle (selon les élevages) et 2 prélèvements à chaque fois :
- 2 sols dans les cases,
- 2 cloisons de séparation des cases à hauteur des animaux (20 cm),
- 2 murs des cases à hauteur des animaux,
- 2 nourrisseurs (intérieur et extérieur),
- 2 murs en hauteur (au-delà de 2 m) ou plafonds,
- 2 tapis de mise-bas (tapis utilisés au moment des mises-bas),
- 2 préfosses ou sous les caillebotis.
Interprétation des résultats
Les résultats sont interprétés selon la grille suivante :
Par site de prélèvement
| Note |
Colonies |
1 |
<
ou =10 |
2 |
]
10 ; 50 ] |
3 |
[50
; 150 ] |
4 |
>
150 |
|
|
10
à 50 colonies |
>150
colonies |
Par élevage
On détermine une note N qui correspond à la moyenne des notes obtenues sur les 5 premiers sites de prélèvements (afin de respecter la méthode IFIP : voir Techni Porc Vol. 29, N°1-2006).
La note N est interprétée de la manière suivante :
N |
Appréciation |
N
< ou = 2 |
Bon |
2
< N |
Moyen |
N
> 2,5 |
Mauvais |
Résultats globaux
La répartition des élevages en fonction de la note N est la suivante :
 |
Environ 15% des élevages sont classés "bons", 55% moyens" et 30% "mauvais".
Par site de prélèvement, nous observons les résultats suivants :
 |
1 : sols
des cases 2 : cloisons de séparation (20 cm) 3 : murs des cases (20 cm) 4 : auges des truies 5 murs à 2 mètres 6 : tapis de mise-bas 7 : sous le caillebotis |
On constate que les zones les mieux lavées et désinfectées sont les cloisons et murs à hauteur des porcelets et, dans une moindre mesure, les sols des cases et les murs en hauteur.
On constate en revanche que les nourrisseurs des truies et surtout les tapis de mise-bas obtiennent des notes élevées (> 3). On peut même constater que les tapis de mise-bas sont presque aussi contaminés que le dessous des caillebotis non lavés et désinfectés dans la plupart des cas !
Enfin (et c'est rassurant !), on constate que plus la note est bonne, et moins l'éleveur déclare avoir de pathologie en maternité (arthrites et/ou diarrhées néonatales sur porcelets et/ou écoulements vulvaires sur les truies).
 |
Etude de cas particuliers
1er cas
Elevage de 1 000 truies en conduite à la semaine, salles de maternités de 25 à 30 places sur caillebotis plastique.
L'éleveur réalise un trempage de 30 minutes à 1 h puis dégrossit et lave (en passant environ 6 minutes/case). Enfin, il applique au canon à mousse le désinfectant mélangé au détergent (afin d'avoir de la mousse).
La note obtenue dans cet élevage est de 3.
 |
2ème cas
Elevage de 300 truies en conduite 3 semaines, salles de maternités de 37 places sur caillebotis plastique.
Réalisation d'un trempage court (< 20 mn) puis application d'un détergent et lavage tout de suite après.
Temps passé pour le lavage : environ 7 minutes/case.
La note obtenue dans cet élevage est de 2,6.
 |
3ème cas
Elevage de 350 truies en conduite 4 semaines, 4 salles de maternités de 16 places (2 sur caillebotis béton, 2 sur caillebotis plastique).
Organisation des maternités :
| M1 (béton) 16 places | M2 (béton) 16 places | Stockage des truies sevrées 32 places | |
| M3 (plastique) 16 places | M4 (plastique) 16 places |
L'éleveur sèvre le mercredi : transfert des truies de M1 vers la salle de stockage puis trempage (rapide), application du détergent et lavage. Pendant le lavage, une autre personne transfère les truies M2 dans la salle de stockage et procède au trempage des salles M2, M3 et M4 (les truies sont encore présentes dans M3 et M4). Les truies gestantes entrent dans les salles M1 et M2 et la salle de stockage est vidée laissant de la place pour les truies restées en M3 et M4.
Résultat : 3,9 (M1 sur caillebotis béton)
 |
Conseils et suivi - Conclusion
1er cas
Conseils donnés à l'éleveur :
- Trempage : application de l'eau au jet à basse pression. Temps de trempage minimum 1 h à 1h30.
- Détergent : application du détergent en fin de trempage. Laisser agir entre 20 minutes et 1 heure. La dose d'utilisation a été vérifiée et était correcte.
- Lavage : l'éleveur peut difficilement passer plus de temps (6 minutes/case).
- Désinfection : la dose d'utilisation du désinfectant était correcte mais le détergent était utilisé comme agent moussant mélangé au désinfectant (mélange base acide pouvant altérer l’efficacité du désinfectant)
Résultats du second contrôle
Un deuxième contrôle a été réalisé 6 semaines plus tard.
La note obtenue est de 2,2.
 |
La révision de la méthode de nettoyage-désinfection (sans augmenter la quantité de produit) a donc permis de réduire la note de manière significative.
2ème cas
La méthode a été revue de la manière suivante :
- Trempage : temps de trempage d'au moins 1 h (contre 20 minutes auparavant).
- Détergent : la quantité de détergent a été augmentée d'environ ¼ afin de respecter les doses préconisées. Il a d'autre part été conseillé à l'éleveur de laisser agir au moins 20 minutes avant de laver
- Lavage : augmentation du temps de lavage à 5 h par salle de 37 (soit 8 minutes par case).
- Désinfection : la dose d'utilisation du désinfectant était correcte.
Un nouveau contrôle de désinfection a été effectué 3 mois plus tard.
Résultat : 2,8
 |
Le 2ème contrôle est donc aussi mauvais que le 1er en termes de note moyenne ! On peut néanmoins constater que la courbe du 2ème contrôle est en dessous de celle du 1er contrôle sauf pour les sols).
Il faut dire qu’il y a eu un problème de personnel dans cet élevage (arrêt maladie d’un des salariés) et le lavage désinfection a été confié à une personne en intérim qui n’a peut être pas bien respecté les consignes. Un nouveau contrôle est prévu en début d’année 2010 quand les choses seront rentrées dans l’ordre.
3ème cas
Conseils donnés à l'éleveur :
- Commencer par vider les maternités M3 et M4 qui nécessitent un temps de trempage moins long car sur caillebotis plastique,
- Augmentation du temps de trempage au moins dans les maternités sur caillebotis béton (M1 et M2).
- Détergent : la quantité à utiliser a été revue et doublée.
- Désinfection : la quantité de désinfectant a été également doublée.
Un nouveau contrôle a été réalisé 1 mois plus tard.
Résultats : 2,8 (M3 : caillebotis plastique) et 3,4 (M1 : caillebotis béton)
 |
Les résultats sont légèrement meilleurs mais restent néanmoins mauvais.
Le temps de trempage n’a malheureusement pu être augmenté. La quantité de détergent à utiliser n’a pas été respectée ainsi que sont temps de contact qui doit être d’au moins 20 minutes.
Avec ce type de conduite (l’entrée des truies en maternité doit être rapide en raison d’un manque de place), il est probablement difficile de faire beaucoup mieux.
Conclusion
La méthode de contrôle du nettoyage désinfection est une méthode assez fiable qui permet d’objectiver une situation initiale et offre une base de discussion à d’éventuels points à revoir. Les pistes de travail sont toujours à déterminer au cas par cas.
Les mesures proposées permettent parfois une amélioration significative de la situation (1er élevage). Néanmoins, dans certains cas, des facteurs limitants comme le personnel ou les bâtiments ( 2ème et 3èmeélevages) constituent un obstacle à l’amélioration de l’efficacité du nettoyage désinfection.
Commentaires
Ce cas décrit une étude de contrôle de l'efficacité du nettoyage désinfection des salles de maternité à l'aide de boîtes contact "flore totale" (méthode IFIP).
Sur la méthode de contrôle
La répartition des élevages est assez équilibrée (15% de bons, 55% de moyens et 30% de mauvais) ce qui permet de penser que la méthode de contrôle du nettoyage – désinfection est bien adaptée aux conditions "normales" d'élevage.
En cas de vide sanitaire long, il est important de ne pas trop attendre après la désinfection pour faire les prélèvements car la flore totale se développe assez vite. C'est pour cette raison que tous les échantillons ont été effectués maximum 48 heures après la désinfection.
La méthode est simple et peut être réalisée par les éleveurs eux-mêmes.
Sur les conseils donnés aux éleveurs (notes N > 2)
- Trempage : la plupart du temps, les temps de trempage sont insuffisants (< 1 h).
Peu d'élevages disposent de rampes de trempage.
- Les quantités de désinfectant utilisées sont souvent respectées mais ce n'est pas une garantie (2 des 3 élevages étudiés utilisaient des doses correctes de désinfectant et néanmoins obtenaient une note mauvaise lors du 1er contrôle).
- Enfin, les canons à mousse ne sont jamais correctement réglés.
Deux caspeuvent se présenter: :
- Le désinfectant n'est pas assez dilué (cas le plus fréquent) et donc la solution appliquée peut ne pas recouvrir toute la surface à désinfecter (surtout pour les surfaces poreuses type béton).
- Le désinfectant est trop dilué et on peut avoir un effet de ruissellement.
Dr Guillaume FRIOCOURT
Vétérinaire
22 - LOUDEAC





